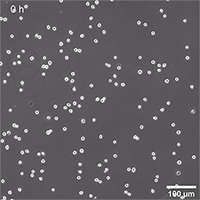
圖片10-.gif

date:2023-01-13 11:17:11
體外細(xì)胞培養(yǎng)是研究細(xì)胞功能、了解疾病和發(fā)現(xiàn)新藥的重要工具。這些實(shí)驗(yàn)中的大部分是在組織培養(yǎng)處理過的塑料器皿中進(jìn)行2D單層細(xì)胞培養(yǎng)。然而,這與活細(xì)胞的體內(nèi)環(huán)境看起來完全不同。細(xì)胞嵌入由其他細(xì)胞和結(jié)構(gòu)組成的組織中,稱為細(xì)胞外基質(zhì)(ECM;圖1A)。細(xì)胞對(duì)細(xì)胞和細(xì)胞對(duì)ECM的相互作用以及這些組織內(nèi)的機(jī)械力對(duì)細(xì)胞形態(tài)和行為有著至關(guān)重要的影響。此外,活體組織中的營養(yǎng)物質(zhì)、代謝產(chǎn)物、氧氣和CO2暴露于3D細(xì)胞結(jié)構(gòu)(例如腫瘤)與2D單層中有非常大的區(qū)別的(圖1B和1C)。

圖1A:活體組織中具有細(xì)胞間接觸和細(xì)胞間ECM接觸的細(xì)胞示意圖。

圖1B:3D腫瘤球體的示意圖,外部為增殖細(xì)胞,內(nèi)部為壞死細(xì)胞,中間為靜止細(xì)胞。外部的氧氣和營養(yǎng)物質(zhì)濃度很高,而內(nèi)部的二氧化碳和代謝廢物含量很高。

圖1C:使用ibidi泵系統(tǒng)灌注培養(yǎng)14天后,L929球體在µ-Slide Spheroid Perfusion, Bioinert中的活/死FDA/PI染色,0.75 ml/min。綠色:活細(xì)胞(熒光素二乙酸酯,F(xiàn)DA);紅色:死細(xì)胞(碘化丙啶,PI)。寬場(chǎng)熒光顯微鏡,10倍物鏡。
研究人員在建立細(xì)胞培養(yǎng)模型以研究細(xì)胞功能、特定疾病(如癌癥)或表征某些藥物之前,必須考慮這些因素。為了獲得最接近體內(nèi)的實(shí)驗(yàn)結(jié)果,盡可能地模擬活體組織的生理?xiàng)l件也是有意義的。
在本文中,我們引入了不同的三維細(xì)胞培養(yǎng)模型來研究細(xì)胞在體內(nèi)的狀態(tài)。
從單層細(xì)胞到組織:
雖然細(xì)胞仍然主要是在細(xì)胞培養(yǎng)處理過的塑料表面或包被蛋白質(zhì)或厚細(xì)胞基質(zhì)(2.5D培養(yǎng))的2D單層中培養(yǎng),但當(dāng)你想用更生理的方式培養(yǎng)細(xì)胞時(shí),你可以選擇各種3D細(xì)胞培養(yǎng)模型(圖2)。可以使用基于支架的技術(shù),如聚合物或水凝膠,它們通過合成化學(xué)聚合物或蛋白質(zhì)網(wǎng)絡(luò)提供結(jié)構(gòu)支持。或者,可以使用無支架技術(shù)獲得3D細(xì)胞結(jié)構(gòu),其中復(fù)雜的細(xì)胞聚集體或整個(gè)組織可以在沒有額外結(jié)構(gòu)支持的情況下形成。

圖2: 2D和3D細(xì)胞培養(yǎng)模型概述
這兩種方法各有利弊,在決定哪種技術(shù)最適合各自的研究問題時(shí),應(yīng)考慮這些利弊。支架方法考慮了細(xì)胞與ECM的相互作用,而懸浮生長的球體可以更好地控制細(xì)胞的環(huán)境。
為了在顯微鏡上進(jìn)行3D結(jié)構(gòu)的長期培養(yǎng)和研究,已經(jīng)開發(fā)了特殊的工具和技術(shù),以確保在長時(shí)間內(nèi)持續(xù)提供介質(zhì)并模擬生理?xiàng)l件。
基于支架的3D細(xì)胞培養(yǎng)模型:
3D細(xì)胞培養(yǎng)模型的支架可以從多孔聚合物膜到模擬ECM細(xì)胞微環(huán)境的復(fù)雜水凝膠。
一般來說,水凝膠形成交聯(lián)聚合物的結(jié)構(gòu),可以吸收和結(jié)合大量的水。在4°C或室溫下,混合物為液體,但在37°C時(shí)會(huì)形成凝膠。這一特性使得液體與細(xì)胞混合成為可能,然后在37°孵育時(shí)將細(xì)胞嵌入3D基質(zhì)中。這使得細(xì)胞能夠保留特定的體內(nèi)特征,例如細(xì)胞ECM相互作用或環(huán)境的生理和機(jī)械特性。
有不同類型的水凝膠,如Matrigel®或膠原蛋白,它們?cè)醋杂袡C(jī)來源。也有復(fù)雜的合成水凝膠,其優(yōu)勢(shì)是能對(duì)其成分(分子、交聯(lián)劑等)進(jìn)行精確的控制。這使其能對(duì)各個(gè)組成部分的影響得出不同的結(jié)論。
無支架3D細(xì)胞培養(yǎng)模型:
支架獨(dú)立方法允許在沒有基質(zhì)支持的情況下在3D中培養(yǎng)細(xì)胞。它們依賴于細(xì)胞自組裝成聚集體或球狀體的概率。為了促進(jìn)這種自組裝過程,人們建立了各種各樣的技術(shù)。

圖 3:在µ-Slide 4 Well中培養(yǎng)的纖維蛋白水凝膠中出牙的人腸成纖維細(xì)胞和內(nèi)皮細(xì)胞球狀體。內(nèi)皮細(xì)胞用CD31染色(黃色),成纖維細(xì)胞用波形蛋白染色(紅色),DNA用DAPI染色(青色)。共焦圖像由H. Nogueira Pinto,生物工程3D微環(huán)境組,Instituto de Investigação e Inovação em Saúde (i3S), Universidade do Porto, Portugal。
懸滴技術(shù)
懸滴技術(shù)是生物學(xué)中行之有效的方法,已用于許多不同的應(yīng)用,如觀察整個(gè)(微觀)生物體或蛋白質(zhì)的結(jié)晶。它利用重力形成懸浮液滴,懸掛在玻璃板上。在過去的十年中,這項(xiàng)技術(shù)已經(jīng)被改進(jìn)并適用于3D細(xì)胞培養(yǎng)的應(yīng)用,能夠從細(xì)胞懸浮液中形成球狀體,而無需支撐支架(圖4)。如今,專門的懸滴板已在市場(chǎng)上銷售。然而,雖然這種方法適用于球狀體的生成,但不可能將其與高分辨率顯微鏡相結(jié)合。

圖 4:懸滴法原理
超低吸附 (ULA) 涂層
所謂的低粘附板是涂有中性電荷或親水性蛋白質(zhì)或水凝膠,可減少細(xì)胞對(duì)板表面的附著,從而形成 3D細(xì)胞結(jié)構(gòu)。盡管這種涂層主要防止細(xì)胞附著,但在更長的時(shí)間后,細(xì)胞粘附仍可能發(fā)生,因?yàn)橥繉油ǔV皇俏锢砦蕉枪矁r(jià)結(jié)合——因此不具有長期穩(wěn)定性。
生物惰性表面
與標(biāo)準(zhǔn)的ULA涂層相比,生物惰性表面是共價(jià)結(jié)合的,并提供穩(wěn)定的表面鈍化。因此,它可以完全防止蛋白質(zhì)或細(xì)胞附著在涂層表面。這促進(jìn)了細(xì)胞間的相互作用和3D細(xì)胞聚集的形成,即使是在長期實(shí)驗(yàn)中(圖5)。

圖5: ibidi聚合物蓋玻片生物惰性表面的球狀體形成
微圖案表面微孔板
在Bioinert表面上壓印微圖案可以使細(xì)胞精確粘附在指定位置(圖6)。

圖6:微圖案點(diǎn)上的細(xì)胞附著動(dòng)態(tài)圖
µ-patterned圖案處周圍的鈍化區(qū)域有助于形成3D細(xì)胞聚集體和球狀體(圖7和8)。

圖7:微圖案點(diǎn)上球體形成的原理
圖8:接種在200 µm粘附點(diǎn)上的NIH-3T3細(xì)胞系懸浮液,64小時(shí)活細(xì)胞成像,相差,4x 物鏡。
具有特殊幾何形狀的微孔板、微流控器官芯片和用于長期3D細(xì)胞培養(yǎng)的設(shè)備
為了體外細(xì)胞培養(yǎng)盡可能接近體內(nèi)條件,與灌注設(shè)備相結(jié)合的微流控器官芯片檢測(cè)變得越來越重要。在這種應(yīng)用中,細(xì)胞被嵌入到微通道中的基質(zhì)中。這些通道可以灌注培養(yǎng)基或藥物,用于在流動(dòng)或藥物篩選下進(jìn)行長期細(xì)胞培養(yǎng)(圖9和10)。
具有特殊幾何形狀的微孔板允許進(jìn)行特定的基于3D細(xì)胞的測(cè)定(如:傷口愈合或趨化性測(cè)定)或模擬不同的器官(如:肺或肝)。

圖9:ibidi µ-Slide Spheroid Perfusion球體灌注的工作原理,它可連接到泵系統(tǒng)(如ibidi泵系統(tǒng)),用于長期培養(yǎng)球狀體

圖 10:L929 成纖維細(xì)胞在 µ-Slide Spheroid Perfusion, Bioinert球體灌注中顯示球狀體形成,,第1-14天,接種濃度5 x 105個(gè)單細(xì)胞/ml。左圖:無灌注,每隔一天更換一次培養(yǎng)基。右圖:使用 ibidi 泵系統(tǒng)灌注,0.75 毫升/分鐘。相差顯微鏡,10 倍物鏡,孔徑 800 µm。
總之,通過從2D細(xì)胞單層到3D細(xì)胞培養(yǎng),已經(jīng)在模擬活體組織的生理?xiàng)l件方面取得了巨大的進(jìn)展。這可以更好地讀取基于細(xì)胞的分析、疾病模型和藥物效應(yīng),從而使細(xì)胞培養(yǎng)總體上更準(zhǔn)確,成為動(dòng)物模型的更好替代品。
ibidi開發(fā)用于3D細(xì)胞模型分析的產(chǎn)品

有關(guān)球體、類器官和3D細(xì)胞培養(yǎng)的更多信息,請(qǐng)查看:ibidi 3D細(xì)胞(球狀體、類器官和單細(xì)胞)培養(yǎng)(←點(diǎn)擊即可查看)。
參考文獻(xiàn):
Kim W, Gwon Y, Park S, Kim H, Kim J. Therapeutic strategies of three-dimensional stem cell spheroids and organoids for tissue repair and regeneration. Bioact Mater. 2022 Apr 4;19:50-74. doi: 10.1016/j.bioactmat.2022.03.039.
Krysko DV, Demuynck R, Efimova I, Naessens F, Krysko O, Catanzaro E. In Vitro Veritas: From 2D Cultures to Organ-on-a-Chip Models to Study Immunogenic Cell Death in the Tumor Microenvironment. Cells. 2022 Nov 21;11(22):3705. doi: 10.3390/cells11223705.
Langhans SA. Three-Dimensional in Vitro Cell Culture Models in Drug Discovery and Drug Repositioning. Front Pharmacol. 2018 Jan 23;9:6. doi: 10.3389/fphar.2018.00006.
Clevers H. Modeling Development and Disease with Organoids. Cell. 2016 Jun 16;165(7):1586-1597. doi: 10.1016/j.cell.2016.05.082.
ICP備案號(hào):
滬ICP備15057650號(hào)-1
 滬公網(wǎng)安備31011202005471
滬公網(wǎng)安備31011202005471
雷萌生物科技(上海)有限公司 保留所有版權(quán).